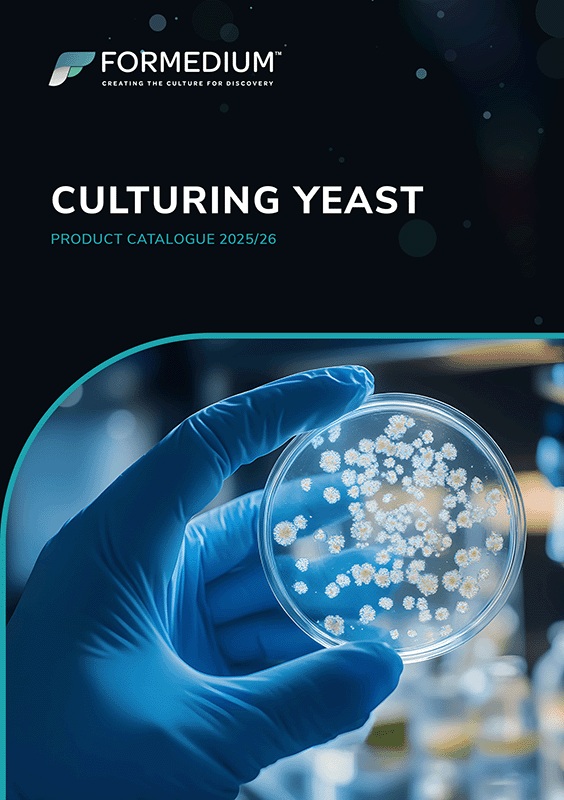
Culturing Yeast

Catalogs from ForMedium
Animal-free Media
Formedium provides a selection of culture media entirely free of animal-derived components, suitable for microbiology and biotechnology applications. These media replace animal-derived components, like Tryptone, with plant-based alternatives such as Soya Peptone, providing essential nutrients for microbial growth. Formedium’s animal-free formulations, including LB Miller, LB Lennox, 2YT, and specialized media for Dictyostelium discoideum, deliver consistent performance comparable to traditional media while supporting ethical research and reducing contamination risks. Released August 2025.
Culturing E. coli - Media, Antibiotics & Buffers
For E. coli research, Formedium supplies an extensive selection of cultivation media, including rich formulations such as LB (Miller, Lennox, L-Broth), Tryptone, Terrific, and Super Broth, as well as Auto-Induction Media for effortless protein expression and Neidhardt MOPS Minimal Medium for defined, reproducible growth. High-quality media components, animal-free alternatives, and a selection of antibiotics such as ampicillin, kanamycin, and chloramphenicol provide flexibility for tailored applications. Released August 2025.
Culturing Yeast - Media, Supplements & Buffers
Formedium supplies a comprehensive selection of culture media for Saccharomyces cerevisiae research, ranging from nutrient-rich Complex Media like YPD to defined formulations such as Yeast Nitrogen Base (YNB) and Synthetic Defined (SD) media. Synthetic Complete (SC) media provide all essential amino acids and vitamins, while Amino Acid Drop-Out Supplements enable targeted selection in auxotrophic strains. High-quality Yeast Media Components like agar, glucose, and peptone allow full flexibility for custom formulations. Released August 2025.
Microbiological Media
Formedium provides microbiological media for a wide range of applications. For Dictyostelium discoideum, options include nutrient-rich Non-Defined Complex Media like HL5, as well as defined FM and enhanced SIH Minimal Media for precise and high-yield growth. Yeast Media Components such as agar, glucose, and peptone allow custom formulations. Fungal options include Aspergillus (complete and minimal) and Fusarium (potato dextrose) media, while MRS agar and broth selectively support Lactobacilli. Released August 2025.
Formedium - Creating the Culture for Discovery
Our partner Formedium specialises in providing blending technology for the manufacturing of industry-standard media and custom nutrient formulations. The highly skilled and agile team enables Formedium to swiftly respond to the evolving needs of their clients in microbial, cell, and bacterial growth research. Formedium combines advanced blending techniques with a deep understanding of product development to deliver tailored solutions that support optimal growth conditions for a wide range of scientific applications. Released August 2025.